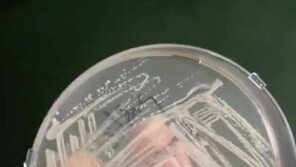

공유하기
공유하기
당신과 가족의 건강을 위한 꿀팁을 헬스동아가 맞춤배송합니다.


1월 7일 경기도 남양주시 퇴계원로175번길, 헤브론교회 앞 ‘맨발 걷기 아미사 힐링하우스’. 유제성 삐땅기의원성형외과 원장(73)은 섭씨 영하의 날씨인 가운데 아내인 문정희 삐땅기의원성형외과 대표와 함께 즐겁게 맨발로 걸었다. 추위를 막기 위해 설치한 비닐하우스 덕분에 영하의 날씨는 전혀 문제가 되지 않았다. 5년 전…

정명교 경남 사천사남초교 교사(30)는 2025년 동아마라톤 올해의 선수상에서 여자부 20·30대 부문 수상자로 선정됐다. 학창 시절 운동을 싫어해 체육 시간이 두려웠던 소녀가 지금은 마라톤 42.195km 풀코스를 거뜬히 완주하는 ‘철녀’로 거듭났다. 정 교사는 지난해 11월 마라톤 풀코스에서 3시간 4분 43초의 개…

키 174cm, 체중 68kg. 작은 체구는 아니었지만, 더 탄탄한 몸을 만들어야 한다고 생각했다. 김강민 서울 중부소방서 119구조대 2팀 구조대장(39)은 특전사(육군특수전사령부) 부사관 시절부터 웨이트트레이닝으로 근육을 키웠다. 6년 3개월 군 생활을 마치고 소방관으로 13년째 활동하면서도 꾸준히 근육 운동을 했다…

‘2024년 6월 18일 오전 10시 시작된 2025 서울마라톤 겸 제95회 동아마라톤 참가 접수가 42.195km 풀코스와 10km가 각각 16분과 45분 만에 마감됐다. 코스당 참가 정원 2만 명, 초 4만 명 모집이 1시간도 안 돼 마감된 것이다. ‘동마’를 비롯해 ‘춘마(춘천마라톤)’, ‘제마(JTBC마라톤)’도…

술자리가 빈번해지는 연말이다. 술을 마시면 라면 생각이 유독 간절해진다. 왜일까?이유는 크게 두 가지다.■ 술 마신 뒤 라면이 생각나는 이유첫째, 저혈당 때문이다.알코올이 몸에 들어오면 간은 이를 해독하기 위해 많은 양의 포도당과 수분을 소비한다. 이 과정에서 혈당이 떨어지고, 그 여파로 뇌에 공급할 에너지가 줄어든다.…

당뇨병(제1·제2형)을 앓는 사람은 돌연 심장사(급성 심장사) 위험이 거의 4배에서 7배 가까이 높으며, 특히 50세 이하 젊은 층의 위험 증가가 두드러진 것으로 나타났다.돌연 심장사는 심장 관련 급성 증상이 갑작스럽고, 예기치 않게 발생하여 1시간 이내 사망하는 것을 의미한다. 생존율이 맺우 낮으며, 생존하더라도 뇌 …

잠옷을 매일 갈아입지 않으면 세균과 바이러스에 감염될 위험성이 커진다는 영국 교수의 주장이 제기됐다. 26일(현지시간) 영국 매체 데일리메일에 따르면 프림로즈 프리스톤 영국 레스터대 임상미생물학 부교수는 “가능하다면 잠옷은 매일 갈아입는 것이 가장 좋다”며 “잠들기 직전 샤워를 하고 땀을 많이 흘리지 않았다면 최대 3~…

중년기(45~64세)와 노년기(65세 이상)에 신체활동을 활발히 하는 사람들은 활동량이 가장 적은 사람들에 비해 치매에 걸릴 위험이 약 40%~45 낮은 것으로 나타났다.몸을 움직이면 정신을 날카롭게 할 수 있다는 사실은 오래전부터 알고 있었다. 신체활동은 뇌로 가는 혈류를 증가시키고, 신경 가소성(뇌가 경험·학습·환경…
헬스장 샤워실 바닥에서 대량의 세균이 검출되자 전문가들이 맨발 샤워를 피하라고 경고했다. 공용 샤워실은 세균·바이러스 감염 위험이 높아 슬리퍼 착용과 위생 관리가 필수다.

2023년 3월 5일 오전 운동하는데 나이 지긋한 어르신들이 맨발로 흙길을 걷고 있었다. ‘맨발로 걸으면 좋나요?’ ‘따라와 봐요. 알려줄게’. 따라나섰더니 ‘가장 좋은 게 잠을 잘 잔다’고 했다. 당시 수면 장애가 다시 시작된 경기 연천경찰서 백학파출소 박경운 경감(56)은 다시 “정말 잠을 잘 자나요?”라고 물었다.…
뉴스레터 구독 해지
뉴스레터 및 마케팅 정보 수신 동의
뉴스레터 구독 서비스를 이용하시기 위해 뉴스레터 및 마케팅 정보 수신 동의가 필요합니다. 동의 하시겠습니까?